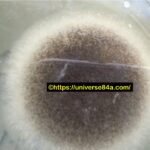
Aspergillus niger: Introduction, Morphology, Pathogenicity, Lab Diagnosis, Treatment, Prevention, and Keynotes

Tag: Microscopy
Aspergillus niger: Introduction, Morphology, Pathogenicity, Lab Diagnosis, Treatment, Prevention, and Keynotes
Introduction Aspergillus niger is a filamentous fungus belonging to the...
Introduction Aspergillus niger is a filamentous fungus belonging to the...
Aspergillus flavus: Introduction, Morphology, Pathogenicity, Lab Diagnosis, Treatment, Prevention, and Keynotes
 Introduction Aspergillus flavus is a filamentous fungus belonging to the...
Introduction Aspergillus flavus is a filamentous fungus belonging to the...
